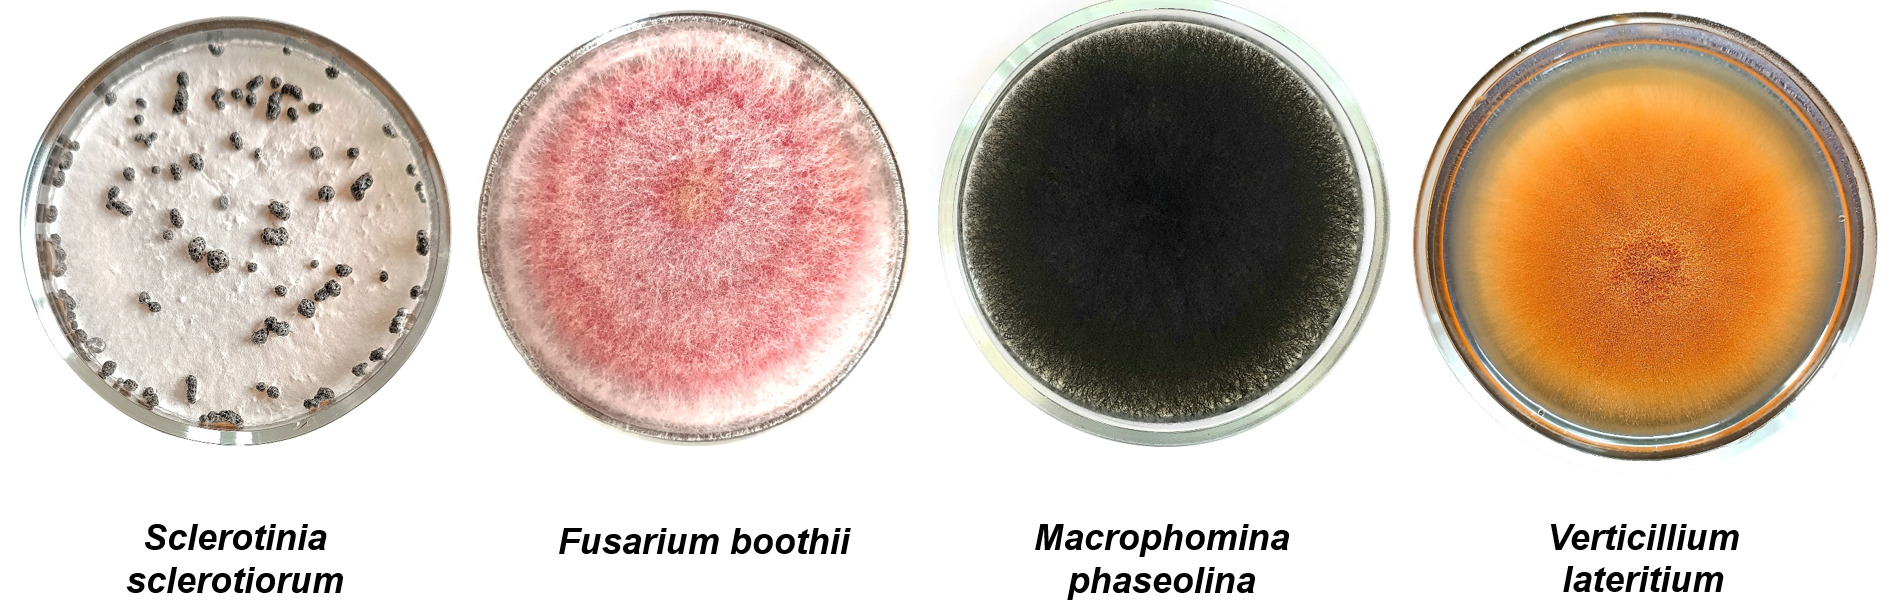
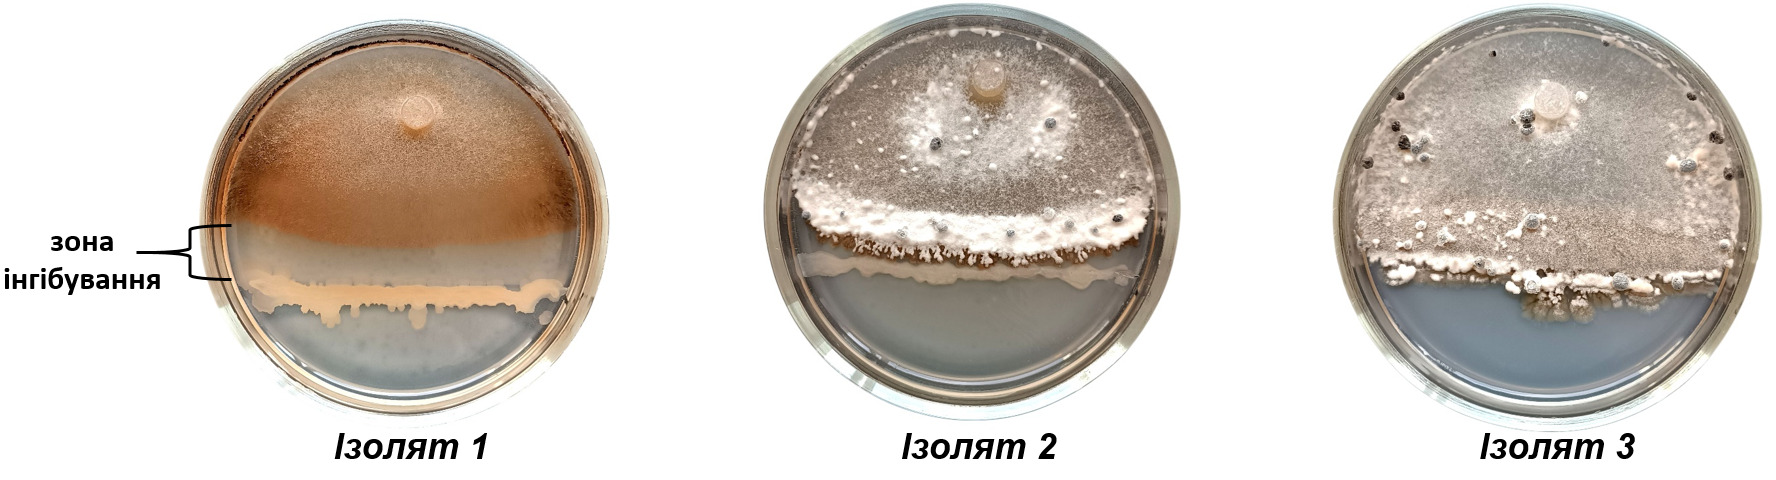
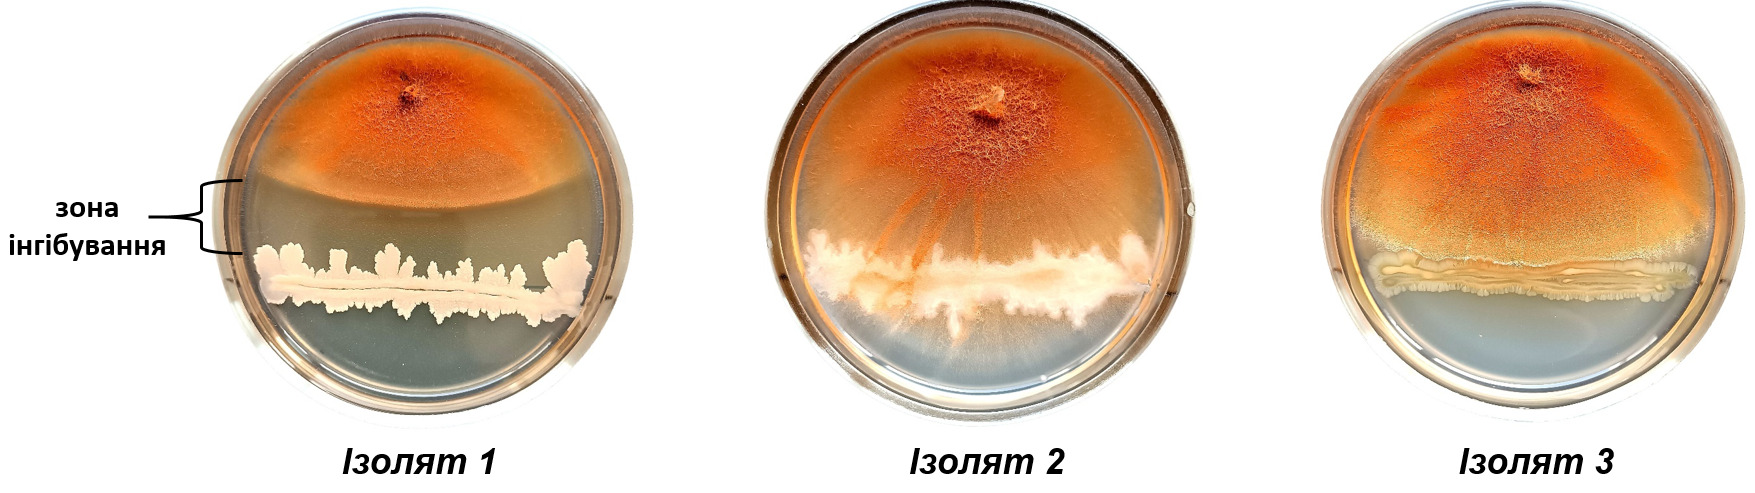
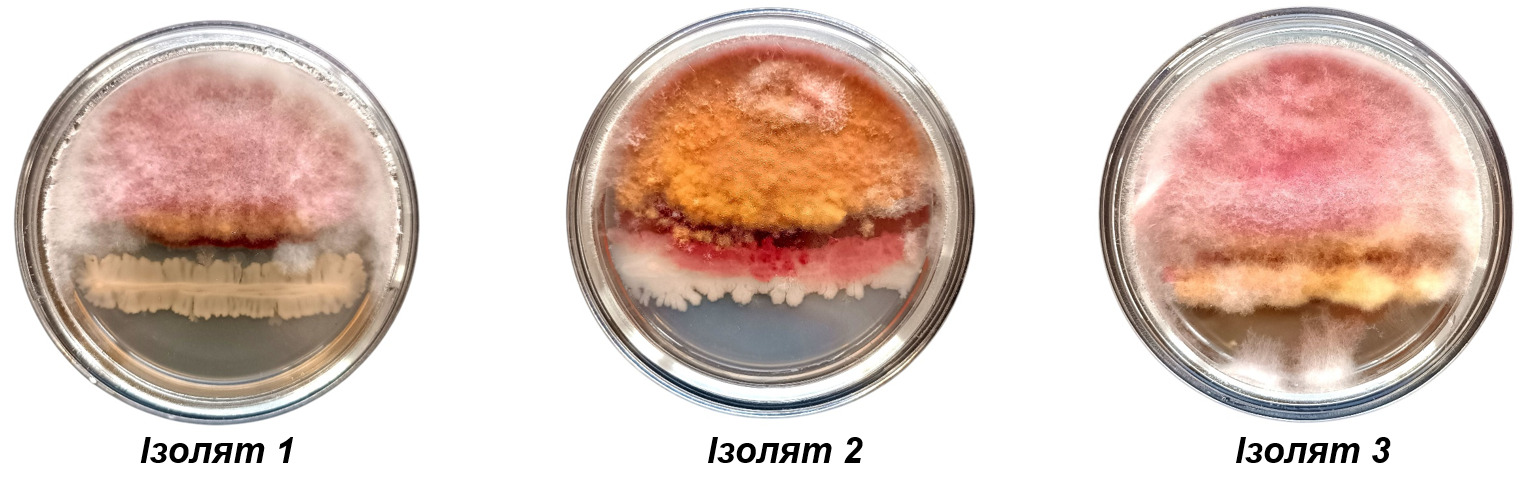

Бактолайв Сід – біопрепарат з вираженими антагоністичними властивостями до фітопатогенів
Розвиток технологій в аграрному секторі еволюціонує неймовірно швидкими кроками. Сучасна техніка для обробки ґрунту, внесення засобів захисту рослин, обмолоту врожаю дає можливість контролювати процеси в полі та отримувати максимальні результати. Однак побудова сівозміни залишається проблемою, адже сільське господарство — це бізнес, який мусить бути ефективним, щоб вижити. Через це аграрії, нехтуючи ключовими принципами сівозміни, часто впроваджують на перший погляд «економічне землеробство».
Сучасні технології в селекції нових сортів та гібридів сільськогосподарських культур дають можливість отримувати стабільно високі врожаї, але існує й інша сторона — падалиця попередньої культури, яка інколи створює значні проблеми в посівах. Український ринок надзвичайно насичений різноманітними засобами захисту рослин, які, здавалося б, можуть вирішити будь-які завдання. Однак патогенні мікроорганізми також розвиваються та адаптуються до сучасних систем захисту. Сьогодні аграрії вже стикаються з хворобами, проти яких дуже складно боротися.
Серед таких захворювань можна виділити інфекції, що проявляться в пізні фази розвитку культури, коли дія протруйника мінімальна або взагалі відсутня. До таких належать фузаріозна та вугільна гнилі, вертицильоз і особливо небезпечний склеротиніоз. Збудник склеротиніозу здатний знищувати рослини від моменту сходів аж до збору врожаю, а втрати можуть сягати 20-30%.
Тож давайте розберемось детальніше. Щоб правильно побудувати технологію захисту сільськогосподарських культур від склеротиніозу, необхідно знати біологічний цикл розвитку патогена.

Рис. 1 Цикл розвитку збудника склеротиніозу (Sclerotinia sclerotiorum)
Збудник склеротиніозу інфікує рослину, і через 8 діб із міцелію всередині неї утворюються склероції розміром 3-12 мм. За підвищеної вологості склероції також формуються на поверхні. Під час обмолоту вони разом із пожнивними решками потрапляють у ґрунт. У стані спокою (склероції) гриб зберігається в ґрунті до 7-10 років, не втрачаючи патогенності.

Рис. 2 Заселення ґрунту склероціями разом із пожнивними рештками
Умовою для проростання склероцій є постійна вологість поверхневого шару ґрунту впродовж 10-14 діб. Для подальшого розвитку необхідна температура ґрунту 7-11 ⁰С. Утворювати плодові тіла (апотеції) здатні лише склероції, розташовані у верхньому шарі ґрунту (0–5 см). Вони формують тонкі стебла із зонтикоподібними верхівками, що піднімаються над поверхнею. Апотеції мають жовто-помаранчеве або коричневе забарвлення та розмір 6–15 мм у діаметрі. За сприятливих умов процес від проростання склероцій до появи апотецій триває 3–4 тижні.
Апотеції містять сумчасті спори — аскоспори, на формування яких більше впливає вологість ґрунту та повітря, ніж температура. Із зонтичних апотецій розлітаються аскоспори та розносяться вітром. Для прикладу на рослинах соняшника при потраплянні на кошик особливо в період цвітіння вони проростають та інфікують рослини. Для проростання спор необхідна достатньо вологи впродовж 16-24 годин та оптимальна температура 15-20 ⁰С. Якщо вологості недостатньо, аскоспори зберігають життєздатність на рослині-господарі до 17 годин.
Другий шлях інфікування проходить із міцелію пророслих склероцій у верхньому шарі ґрунту. В такому випадку коренева система та вегетативна маса прикореневої зони інфікуються склеротиніозом. Висока температура навесні сприяє проростанню склероцій, і вже у травні-червні можуть утворюватися апотеції. За сухого ґрунту їхнє формування неможливе. У випадку засухи апотеції зморщуються та припиняють спороношення, але після зволоження знову набухають і відновлюють його. Умовою для сильного інфікування посівів є добре прогрітий ґрунт в квітні, рясні опади наприкінці травня та наявність на поверхні ґрунту три або більше апотецій на 1 м2. На інфікованих рослинах не утворюються спори які розповсюджують інфекцію. Під час вегетації збудник поширюється лише контактним шляхом, утворюючи в посівах окремі вогнища заражених рослин.
Склеротиніоз має широкий спектр рослин-господарів із більш ніж 360 видів дводольних рослин. Серед сільськогосподарських культур це хрестоцвіті, бобові, пасльонові, зонтичні та інші.
Отже, склеротиніоз це хвороба, джерелом інфекції якої є склероції в ґрунті, а зараження кореневої зони та вегетативної маси може відбуватися протягом усього вегетаційного періоду. Оскільки хімічні засоби безсилі проти ґрунтової інфекції під час вегетації, перспективним напрямом є розробка мікробіологічних препаратів. Вони діють через антагоністичні взаємозв’язки з патогенами, захищаючи кореневу систему.
На ринку України представлені препарати з подібним складом, але їхня ефективність різна та не завжди стабільна. Якість продукту залежить від технологій, використаних науковою установою-розробником. Сучасна селекція дозволяє створювати мікроорганізми, сумісні з більшістю протруйників, що забезпечує ефективність препарату та зберігання обробленого насіння до трьох місяців.
На ринку України компанія HIMAGRO M пропонує аграріям мікробіологічний препарат від німецького виробника RHIZO-MIC GmbH Бактолайв Сід. До складу препарату входять спеціальні концентрації корисних ризосферних бактерій (п’ять різних видів Bacillus) та ризосферного гриба Trichoderma harzianum. Крім того, вільноживучі види Azospirillum, що фіксують азот, Pseudomonas, що розчиняють недоступні форми фосфору.
Науково-дослідний центр компанії «KERNEL» перед проведенням польових дослідів, попередньо проводить лабораторні тестування біологічних препаратів в своїй мікробіологічній лабораторії на їх життєздатність та заявлений титр біоагентів. Пропонуємо ознайомитись із результатом тестування мікробіологічного препарату Бактолайв Сід.
Для визначення антагоністичних властивостей біоагентів препарату використано чисті культури фітопатогенних грибів :
Рис. 3 Чисті культури збудників хвороб
Висіявши біологічний препарат Бактолайв Сід на поживні середовища вдалося виділити в чисті культури гриб Trichoderma harzianum та цілий ряд бактерій з різними морфологічними ознаками, ідентифікація яких поки що неможлива. Для дослідження відібрані три види бактерій із назвами Ізолят 1, Ізолят 2, Ізолят 3.
Рис. 4 Антагоністична взаємодія бактеріальних біоагентів препарату Бактолайв Сід з фітопатогенним мікроміцетом Sclerotinia sclerotiorum, 21 доба росту
Рис. 5 Антагоністична взаємодія бактеріальних біоагентів препарату Бактолайв Сід з фітопатогенним мікроміцетом Verticillium lateritium, 21 доба росту

Рис. 6 Антагоністична взаємодія бактеріальних біоагентів препарату Бактолайв Сід з фітопатогенним мікроміцетом Macrophomina phaseolina, 21 доба росту
Рис. 7 Антагоністична взаємодія бактеріальних біоагентів препарату Бактолайв Сід з фітопатогенним мікроміцетом Fusarium boothii, 21 доба росту
Серед протестованих ізолятів бактеріальних біоагентів препарату Бактолайв Сід із фітопатогенами, Ізолят 1 проявляє виражену антагоністичну активність проти фітопатогенів, утворюючи чітку зону інгібування, утворення склероцій грибів Sclerotinia sclerotiorum не спостерігається. Інші ізоляти проявляють низьку антагоністичну активність, не утворюючи видимої зони інгібування, а фітопатоген атакує/наростає на бактеріальну культуру.

Рис. 8 Антагоністична взаємодія грибного біоагенту (Trichoderma harzianum) препарату Бактолайв Сід з фітопатогенними грибами, 21 доба росту
Штам Trichoderma harzianum, виділений з препарату Бактолайв Сід, продемонстрував антагоністичну активність до фітопатогенних грибів Verticillium lateritium та Fusarium boothii проявляє антагонізм переважно за типом конкуренції за субстрат. А по відношенню до фітопатогенних грибів Sclerotinia sclerotiorum та Macrophomina phaseolina продемонстрував кращу антагоністичну активність, проявивши гіперпаразитизм – Trichoderma harzianum наростає на фітопатогенні гриби та живиться ними.
Отже, проаналізувавши мікробіологічний склад препарату Бактолайв Сід, ми виявили, що штам гриба Trichoderma harzianum, та Ізолят 1 проявляють виражену антагоністичну дію проти патогенних мікроорганізмів. Ізолят 2 та Ізолят 3 проявляють дуже слабку антагоністичну дію, а подекуди вона відсутня. Це свідчить, що виробник помістив дані мікроорганізми для виконання інших цілей, таких як стимуляція росту та розвитку культури, розчинення поживних речовин в ґрунті та переведення їх в доступну форму для рослин.
Коментар від представника компанії RHIZO-MIC GmbH, DR. Ewald Sieverding. «Практична цінність мікробіологічного препарату Бактолайв Сід полягає не лише в антагоністичних властивостях та перетворенні важкорозчинних елементів живлення, але й у забезпеченні рослин фітогормонами (ауксини, гібереліни, цитокініни), вітамінами (тіамін, рибофлавін, піридоксин, фолієва кислота) та амінокислотами (аланін, аспаргінова кислота, валін, гістидін, ізолейцин, лізин, пролін). Заселення корисною мікрофлорою кореневої системи рослин забезпечує постійне надходження фізіологічно активних речовин, що значно ефективніше за одноразове використання фітогормональних препаратів. В результаті рослини краще протистоять стресовим умовам, таким як коливання вологості ґрунту, екстремальні температури та посухи, які нерідко супроводжують вегетаційний період».
Використання мікробіологічних препаратів в інтенсивних технологіях вирощування це надійний та обов’язковий захід для обмеження розвитку патогенів, стимуляції розвитку сільськогосподарських культур і зменшення хімічного навантаження на ґрунт та урожай.